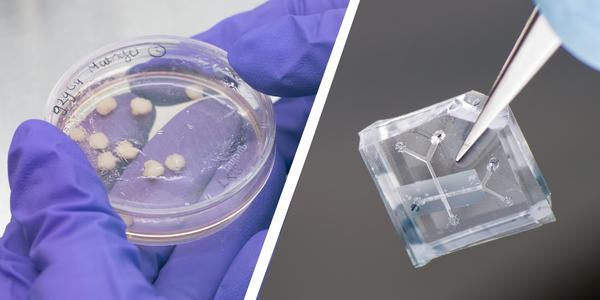
Organoids en orgaan-op-chip

In January 2023, the first master course on “How to use animal-free innovations in biomedical research” took place at the VU Amsterdam. This course was created by Birgit Goversen, postdoctoral researcher at the Amsterdam UMC and a previous guest in our podcast. The course offers students a comprehensive overview of the research process without the use of animals.

Animal-free journey through all facets of research
In the course, Birgit takes students on a journey through all facets of the research process, but in a non-animal way. With this course, Birgit aims to make students aware of the limits of current experimental animal models and wants to teach them about the possibilities of animal-free innovations.
During the course, students will work on research questions with corresponding non-animal methods, and on making a research plan. In addition, they attend master classes and journal clubs on the practical challenges associated with animal-free innovations.
Furthermore, the course focuses on the status of non-animal innovations in the biomedical field, the steps needed to put non-animal innovations into practice and the influence of different stakeholders in the biomedical field.
Permanent part of the curriculum
The first edition of this course in January, was a pilot to investigate whether the course could be continued. Fortunately, this is the case and the course will become part of the permanent curriculum of the master’s in Personalised Medicine at VU University Amsterdam starting from the 2023-2024 academic year.
Wonderful collaboration
We are thrilled to contribute to this animal-free master’s course. For the development of this course, we have therefore made a financial contribution of €10,000. And in addition, our colleague, Saskia Aan, has given a lecture during this master course, about Proefdiervrij’s views on animal-free innovations.
“It is fantastic that this course is becoming part of the curriculum at VU Amsterdam. The course started in January with a small group of students, and I could see a lot of potential in it for the future. I’m looking forward to future editions!”
Saskia Aan, Science & Innovation Advisor.

Animal-free course contributes to world without laboratory animals
By developing a critical perspective towards different research methods, students can learn how to improve non-animal methods and ensure that non-animal innovations are implemented faster. In this way, they contribute to a world without animal testing.
This animal-free master’s course is an exciting and necessary step to promote animal-free alternatives in biomedical research. We look forward to more courses like this in the future and hope it will help the next generation of scientists to create a more ethical and sustainable world.



